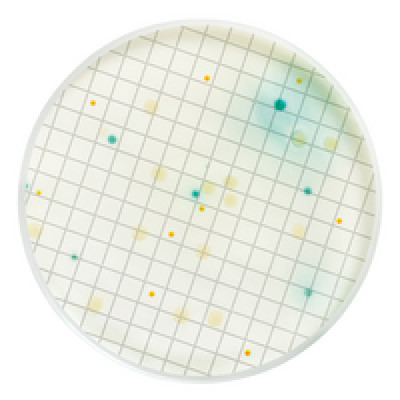
Los Angeles

MEIO PSEUDOMONAS EM AMPOLA 2ml (CX) MILLIPORE
Modelo: MHA000P2P
-
R$934,60
ou até 3x de R$311,53 sem juros
Economize 5% no PIX: R$887,87
ou 3.5% no boleto: R$901,89
Descrição
MEIO PSEUDOMONAS EM AMPOLA 2ml MILLIPORE
CX C/ 50 UND
CX C/ 50 UND